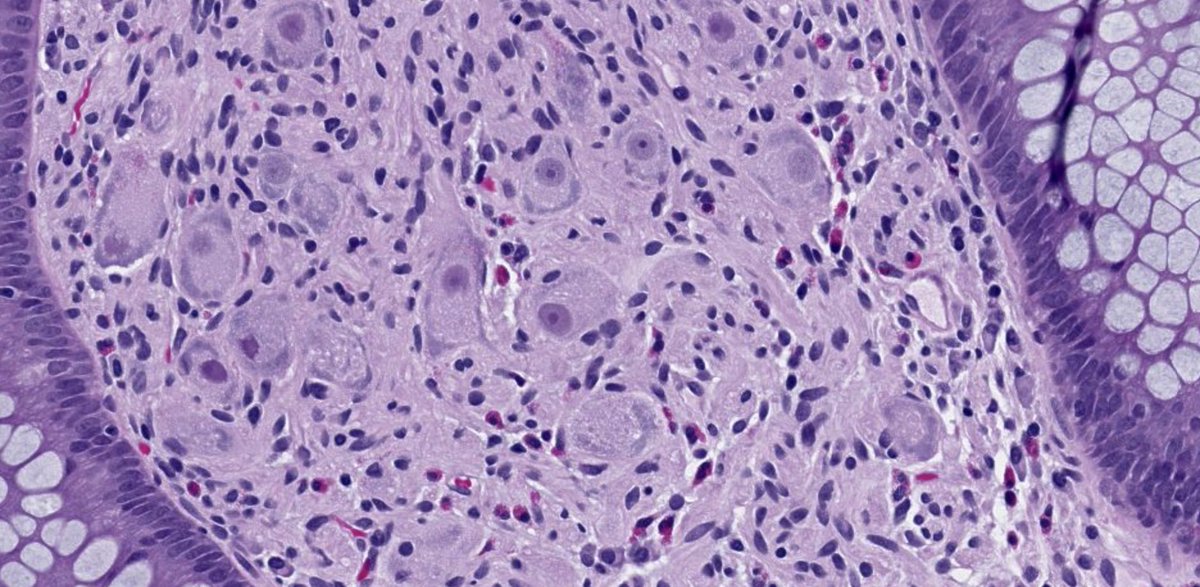
drtimbracey's tweet image. 1cm polyp at anastamotic site of previous colectomy. What’s the diagnosis and the potential associated syndrome? #pathtwitter #GIPathology

#colonpolyps search results
Eating for a healthy colon and preventing #ColonPolyps and #ColorectalCancer - hear from @kzeratsky, a registered dietitian nutritionist, in this #MayoClinicMinute. mayocl.in/2Gp4wFH
Mayo Clinic digestive care specialist Dr. Ajay Singh explains why regular screening to identify and remove #ColonPolyps is so important. #ColonCancer @MayoCancerCare mayocl.in/3VaRf6h
Mayo Clinic gastroenterologist Dr. Ajay Pal Singh answers 6 common questions about #ColonPolyps in @MayoCancerCare's latest blog. #crcsm mayocl.in/3xxSP9b
#ArtificialIntelligence could help #doctors identify hard-to-spot #colonPolyps ow.ly/iM5Z30mzsl3 #AI #AInews #Algorithm #ML #MachineLearning #cancer @ahier @jnasr @lpcampi @IrmaRaste @JohnNosta @daniel_kraft @MentorHealth1 @protoninfo @eViRaHealth @LeadHealthy

Analysis of the Pathological Examination Results of 100 #ColonPolyps Cases after EMR or ESD Operation More @ suo.im/5nllOo
Wonderful #podcast #colonpolyps discussion bowel prep, cscope reports & polyp surveillance by Dr.Maranki @jenmarankimd 👌🏽

So proud of @RahulKarnaMD for leading this very important work now in @AGA_CGH ! ✅ Role of #FIT as a surveillance tool in pts w history of #ColonPolyps Grateful to @AasmaShaukatMD for her mentorship
🔥 Can #FIT test be used for surveillance in 👨🚒 with hx of #polyps ✂️ & Fhx of #CRC ? Check out 👇 our SR in prestigious @AGA_CGH journal So grateful 🙏 to @BilalMohammadMD @AasmaShaukatMD @samirguptaGI for mentorship & support of all co-authors cghjournal.org/article/S1542-…

My poster looks amazing! #AMIA2012 #colonpolyps twitpic.com/bam597
Do you know the symptoms of #ColonPolyps? Anemia, weight loss, and changes in bowel movement patterns are just a few. Find out more at our website: bit.ly/2F3maOD
Do colon polyps always = colon cancer? Not necessarily. @SKamath_MD, medical oncologist at the @clevelandclinic, breaks down #colonpolyps versus cancers here: bit.ly/3ie6nyl #coloncancer #colorectalcancer #colorectalcancerawarenessmonth

What to know about #colonpolyps: bit.ly/2KCoQBM @FocusedonHealth #endcancer
Too much sitting tied to higher risk of #colonpolyps in #men medx.cc/302204429
#CalciumSupplements May Raise the Risk of #ColonPolyps, New Study Finds consumerreports.org/dietary-supple…
So proud of @nataliejowilson for winning 🔥🔥 the @ASGEendoscopy @VideoGIE ‘Outstanding Manuscript Award’! 🏆 #DDW2024 📹 “Use of the #Endorotor Device for Resection of Scarred #ColonPolyps” shows step by step device setup and highlights case examples tinyurl.com/yeew9tbz


Do UK surveillance guidelines catch more #colonpolyps than the US? yhoo.it/T8q4X9 #screeningsaves #coloncancer
T-1 hour 🔥🔥 for the combined @AmerGastroAssn @ASGEendoscopy #PGCourse Breakout Sessions Join us in #Room32 for all things #ColonPolyps #EMR vs #ESD #DDW2025 @DDWMeeting
As #DDW2025 gets closer, Not to Miss the historical 1st comb @ASGEendoscopy & @AmerGastroAssn #PGCourse🔥 👏 to ⭐️ course directors @ibdgijami @ruben_hernaez @ckdilly @alerepici #NagiReddy for a ✅ program Little 🦜told me the #EMR vs #ESD talk is where the cool kids will be 😎

Colon polyps are clumps of cells that form on the lining of the colon. Submissions are open for the upcoming issue. Submit to: [email protected] Visit us: maplespub.com/journal/journa… #fierypolyps #colonpolyps #colon #abnormalcellgrowth

Standing room only at #acsCC18 #colonpolyps everything you need to know about advance management of colorectal lesions @Sangwleemd @HrabeMd @JeffreyMilsomMD @ConorDelaneyMD @dubaicolorectal @DrMikeValente @JeremyLipman @JeffPonskyMD @DavidLiskaMD @drivadeneiramd



Do you have your #coloncare plan in place? Make #TheColonVitamin part of your daily plan. Start now: hubs.ly/H01VchS0 #colonpolyps
Had 30 colon polyps removed. Still no results after 12 days! Is it no news is good news or it’s taking longer because somethings there? #colon #colonpolyps #colorectalcancer
@MyViome & @scrippsresearch Launch At-Home RNA Test to Prevent Colon Cancer aitech365.com/healthcare/lif… #AITech365 #colonpolyps #LifeScience #news #precisionnutrition #RNA #RNAbaseddiagnostics #Viome
aitech365.com
Viome & Scripps Launch At-Home RNA Test to Prevent Cancer
Viome, and Scripps Research, announced a strategic partnership to develop and clinically validate the first at-home RNA test designed...
Did you know that most colon polyps aren`t cancerous? However, if you`re noticing bleeding or other unusual bowel symptoms, it`s important to consider a colonoscopy. Learn more at atgastro.com #colonpolyps #colonoscopy #brooklyn #atlanticgastroenterology #NY

T-1 hour 🔥🔥 for the combined @AmerGastroAssn @ASGEendoscopy #PGCourse Breakout Sessions Join us in #Room32 for all things #ColonPolyps #EMR vs #ESD #DDW2025 @DDWMeeting
As #DDW2025 gets closer, Not to Miss the historical 1st comb @ASGEendoscopy & @AmerGastroAssn #PGCourse🔥 👏 to ⭐️ course directors @ibdgijami @ruben_hernaez @ckdilly @alerepici #NagiReddy for a ✅ program Little 🦜told me the #EMR vs #ESD talk is where the cool kids will be 😎

Colon polyps are more likely to develop in older people and are usually harmless. Screening is necessary to determine if polyps are cancerous. Learn more at atgastro.com #colonpolyps #brooklyn #atlanticgastroenterology #NY

Colon polyps are small growths on the inner lining of the colon that can be benign or precancerous. At Jayanthi Hospitals, we offer different kinds of treatment for Colon Polyps including advanced screening and removal of polyps through colonoscopy. #ColonHealth #ColonPolyps

#Diet plays a crucial role in the development of #colonpolyps! 🚫 A diet high in #processedfoods, #redmeat, and saturated fats 🥩🍔 increases the risk of #polyps. Know more: bit.ly/3XzoK5E #HealthyColon #GutHealth #Gastroenterology #PACEHospitals #Hyderabad #India

Understanding Colon Polyps: Types, Risks, and Prevention 🏥🔍 Learn more about their impact on your health. verywellhealth.com/what-are-the-d… #ColonPolyps #ColonCancer #Gastroenterology #ColorectalScreening #Colonoscopy #ScreeningColonoscopy #ReddingGastroCare

Early detection is key! 🔑 Learn about the signs of polyps. 🔍 Take charge of your health! 💪 Book an appointment today: bit.ly/3Q0BDBX #GIPartnersOfIllinois #ColonPolyps #ColonCancer #Colonoscopy

At Redding GastroCare, we offer the best gastrointestinal services to diagnose and treat a wide range of issues, including #Colonoscopy, #AcidReflux, Intestinal Pain, and #ColonPolyps. Your digestive health is our priority! #ReddingGastroCare #ColonoscopyScreening #AcidReflux

Those Polyps Can No Longer Hide Colon polyps can be diagnosed and treated with endoscopic surgery. Learn about the outpatient resection options available and take action for a healthier lifestyle. #colonpolyps #endoscopicsurgery #mackinawsurgery zurl.co/HPfv

#MasterClass on #ColonPolyps Happening right now @AmCollegeGastro #ACG2024 ⭐️studded panel #DougRex #UzmaSiddiqui @EndoscopyOthman EMR vs ESD 🔪 ⭕️Surgery vs Advanced Endoscopic resection ⭕️Beyond the guidelines ⭕️East 🤝 West perspective


As #GIs, we all encounter Large #ColonPolyps needing #EMR ✳️ Several techniques available (🔥, 🥶💧 EMR) ✅ In this review, we (alongside #HeikoPohl) summarize a Polyp Tailored Resection Strategy 🙏 to @AGA_CGH & @PrasadIyerMD for the opportunity 👉 cghjournal.org/article/S1542-…

#ColonPolyps often go unnoticed, but certain symptoms can be early warning signs. Watch out for these 8 symptoms: rectal bleeding, changes in stool color, bowel habit changes, pain, weakness, weight loss, iron deficiency, and fatigue. Learn more: msn.com/en-us/health/o…

How Pseudopolyps Differ From Colorectal Polyps.. verywellhealth.com/pseudopolyps-8… #ColonPolyps #gastroenterologist #colon #rectalsurgeons #IBD #Pseudopolyps #colonoscopy

1cm polyp at anastamotic site of previous colectomy. What’s the diagnosis and the potential associated syndrome? #pathtwitter #GIPathology

Artron Fecal Occult Blood (#FOB) Test is a rapid and convenient immunoassay for the qualitative detection of #hemoglobin in human fecal samples. It is intended for professional use as an aid to diagnose #colonpolyps, colorectal carcinoma, ulcerative colitis, and Crohn’s disease.

Fecal occult blood (#FOB) refers to hidden blood in the feces. The presence of #hemoglobin indicates internal bleeding associated with the pathological conditions of gastrointestinal tract such as #colonpolyps, #colorectalcarcinoma, #ulcerativecolitis and #Crohn’s disease. #IVD

So proud of @nataliejowilson for winning 🔥🔥 the @ASGEendoscopy @VideoGIE ‘Outstanding Manuscript Award’! 🏆 #DDW2024 📹 “Use of the #Endorotor Device for Resection of Scarred #ColonPolyps” shows step by step device setup and highlights case examples tinyurl.com/yeew9tbz


تعتبر معظم #زوائد_القولون غير ضارة، ولكن يمكن أن تتحول بعض هذه الزوائد مع مرور الوقت إلى سرطان القولون عافاكم الله.. تعرف على أسباب وأعراض زوائد القولون من هنا: #dailymedicalinfo #Colonpolyps dailymedicalinfo.com/view-disease/%…
What are #ColonPolyps and what do they mean for your #health? bit.ly/2cpZecA #ColonHealth #ColonCancer #GIHealth #Houston #KatyTX

Prevention, Detection & Treatment of ... - VIDEO-> bestcancer.solutions/prevention-det… #BillingsClinic #BretMurray #ColonPolyps #Colonoscopy

How does having a family history of #colonpolyps affect you as a #millennial and how does it change the timing of when you need to get screened for colorectal cancer? @SKamath_MD answers this + MORE: bit.ly/3aPLj0w #colorectalcancer

My poster looks amazing! #AMIA2012 #colonpolyps twitpic.com/bam597
Wonderful #podcast #colonpolyps discussion bowel prep, cscope reports & polyp surveillance by Dr.Maranki @jenmarankimd 👌🏽

So proud of @nataliejowilson for winning 🔥🔥 the @ASGEendoscopy @VideoGIE ‘Outstanding Manuscript Award’! 🏆 #DDW2024 📹 “Use of the #Endorotor Device for Resection of Scarred #ColonPolyps” shows step by step device setup and highlights case examples tinyurl.com/yeew9tbz


Do colon polyps always = colon cancer? Not necessarily. @SKamath_MD, medical oncologist at the @clevelandclinic, breaks down #colonpolyps versus cancers here: bit.ly/3ie6nyl #coloncancer #colorectalcancer #colorectalcancerawarenessmonth

Dear #GIPath #colonpolyps Do you report or make any comment on colonic adenoma with increased IEL, there were 6 adenomas In this case, I also have on adjacent normal colonic mucosa. Not all adenomas show the IEL



Fantastic 🔥🔥 talk by the incredible @DennisYangMD on management of large #ColonPolyps at the @AmCollegeGastro Regional #PGCourse and bonus session to get to hangout w him ! @spaulliver @JessPhilpottMD



How to Combat Colon Polyps - Dr. John McDougall #drjohnmcdougall #colonpolyp #colonpolyps #coloncancer praxiom.org/colon-cancer-r…

#Colonpolyps are growths that can form in the lining of the #colon or #rectum. While many polyps are harmless, some types have the potential to become a serious #health concern. Read More: lnkd.in/dsRj8WxB and contact on 9826014491 #gastroenterology #gastroenterologist

Artron Fecal Occult Blood (#FOB) Test is a rapid and convenient immunoassay for the qualitative detection of #hemoglobin in human fecal samples. It is intended for professional use as an aid to diagnose #colonpolyps, colorectal carcinoma, ulcerative colitis, and Crohn’s disease.

Colon polyps can be painful or silent without any symptoms. You can prevent them from turning cancerous with timely screening and removal by #polypectomy. Read more: bit.ly/2GYbxMw #colonoscopy #colonpolyps #YashodaHospitals

As #GIs, we all encounter Large #ColonPolyps needing #EMR ✳️ Several techniques available (🔥, 🥶💧 EMR) ✅ In this review, we (alongside #HeikoPohl) summarize a Polyp Tailored Resection Strategy 🙏 to @AGA_CGH & @PrasadIyerMD for the opportunity 👉 cghjournal.org/article/S1542-…

Fecal occult blood (#FOB) refers to hidden blood in the feces. The presence of #hemoglobin indicates internal bleeding associated with the pathological conditions of gastrointestinal tract such as #colonpolyps, #colorectalcarcinoma, #ulcerativecolitis and #Crohn’s disease. #IVD

Research suggests that following a healthy eating plan and limiting certain foods can reduce your chances of developing colon polyps. Maintaining a healthy body weight can help reduce the risk. #colonpolyps #brooklyn #atlanticgastroenterology #NY

Эндоскопия кишечника при полипах dr-endoscopy.ru/articles/endos… #Health #Polyps #Colonpolyps #Endoscopy #Colonendoscopy

Evalution of the Patients with Colon Polyps in Terms of Helicobacter pylori with Sydney Criteria You can see the free full text of the research by Çağrı Akalın et al. #Helicobacterpylori #Sydneycriteria #colonpolyps #glandular #atrophy 🔹cms.galenos.com.tr/Uploads/Articl…

Those Polyps Can No Longer Hide Colon polyps can be diagnosed and treated with endoscopic surgery. Learn about the outpatient resection options available and take action for a healthier lifestyle. #colonpolyps #endoscopicsurgery #mackinawsurgery zurl.co/HPfv

Standing room only at #acsCC18 #colonpolyps everything you need to know about advance management of colorectal lesions @Sangwleemd @HrabeMd @JeffreyMilsomMD @ConorDelaneyMD @dubaicolorectal @DrMikeValente @JeremyLipman @JeffPonskyMD @DavidLiskaMD @drivadeneiramd



Something went wrong.
Something went wrong.
United States Trends
- 1. #UFC327 N/A
- 2. Cam Young N/A
- 3. #GenocidalNetanyahu N/A
- 4. #FuryMakhmudov N/A
- 5. Rory N/A
- 6. Anthony Joshua N/A
- 7. Cameron Young N/A
- 8. Conor Benn N/A
- 9. Luque N/A
- 10. Shane Lowry N/A
- 11. #TheMasters N/A
- 12. Senga N/A
- 13. #RaiseIt N/A
- 14. Gastelum N/A
- 15. Radtke N/A
- 16. Swalwell N/A
- 17. Sam Levinson N/A
- 18. Prado N/A
- 19. Lindor N/A
- 20. Wacha N/A






































